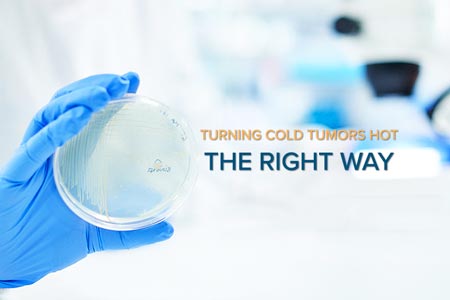

OncoSec Medical Incorporated (OncoSec) (NASDAQ:ONCS), a company developing intratumoral cancer immunotherapies, today announced that it has entered into a research collaboration agreement with the University of California, Los Angeles (UCLA) on behalf of Roger S. Lo, M.D., Ph.D. and his research team.
Dr. Roger S. Lo, Professor of Medicine and Molecular and Medical Pharmacology in the UCLA David Geffen School of Medicine, Associate Chief of Dermatology and a member of the UCLA Jonsson Comprehensive Cancer Center, is a preeminent physician-scientist widely recognized for his work in understanding treatment-resistant melanoma.
Under the research collaboration, Dr. Lo and his research team will perform genetic, transcriptomic and methylomic analyses of patients in OncoSec's PISCES/KEYNOTE-695 Phase 2b clinical trial, which is evaluating TAVO (tavokinogene telseplasmid) in combination with KEYTRUDA® (pembrolizumab) for the treatment of metastatic melanoma in patients that have progress after receiving all available treatments including anti PD-L1 checkpoint immunotherapy.
"UCLA and Dr. Lo represent an ideal collaborator for OncoSec to augment our ongoing PISCES/KEYNOTE-695 Phase 2b clinical program with specialized research designed to pinpoint the genetic and epigenetic mechanisms that correspond to specific clinical outcomes in the treatment of metastatic melanoma with TAVO in combination with pembrolizumab," said Christopher G. Twitty, Chief Scientific Officer of OncoSec. "The PISCES/KEYNOTE-695 Phase 2b study continues to progress as planned with enrollment in Stage 1 expected to be complete in the third quarter 2018 and topline data anticipated prior to year-end. Our collaboration with Lo Lab has the potential to not only offer important insights into the mechanism of action of TAVO in combination with pembrolizumab for the treatment of metastatic melanoma, but could be applicable across our clinical pipeline, including the ongoing KEYNOTE-890 Phase 2b trial of TAVO in combination with pembrolizumab in triple negative breast cancer."
Under Dr. Lo's direction, his research team focuses on genomic, epigenomic and immunologic factors that shape the cancer's evolution on molecularly targeted therapies and/or immune checkpoint inhibitors. Dr. Lo's research has received funding from the National Cancer Institute, American Skin Association, Melanoma Research Alliance, The Melanoma Research Foundation, Ressler Family Foundation, and Steven C. Gordon Family Foundation.
For more information, please visit www.oncosec.com